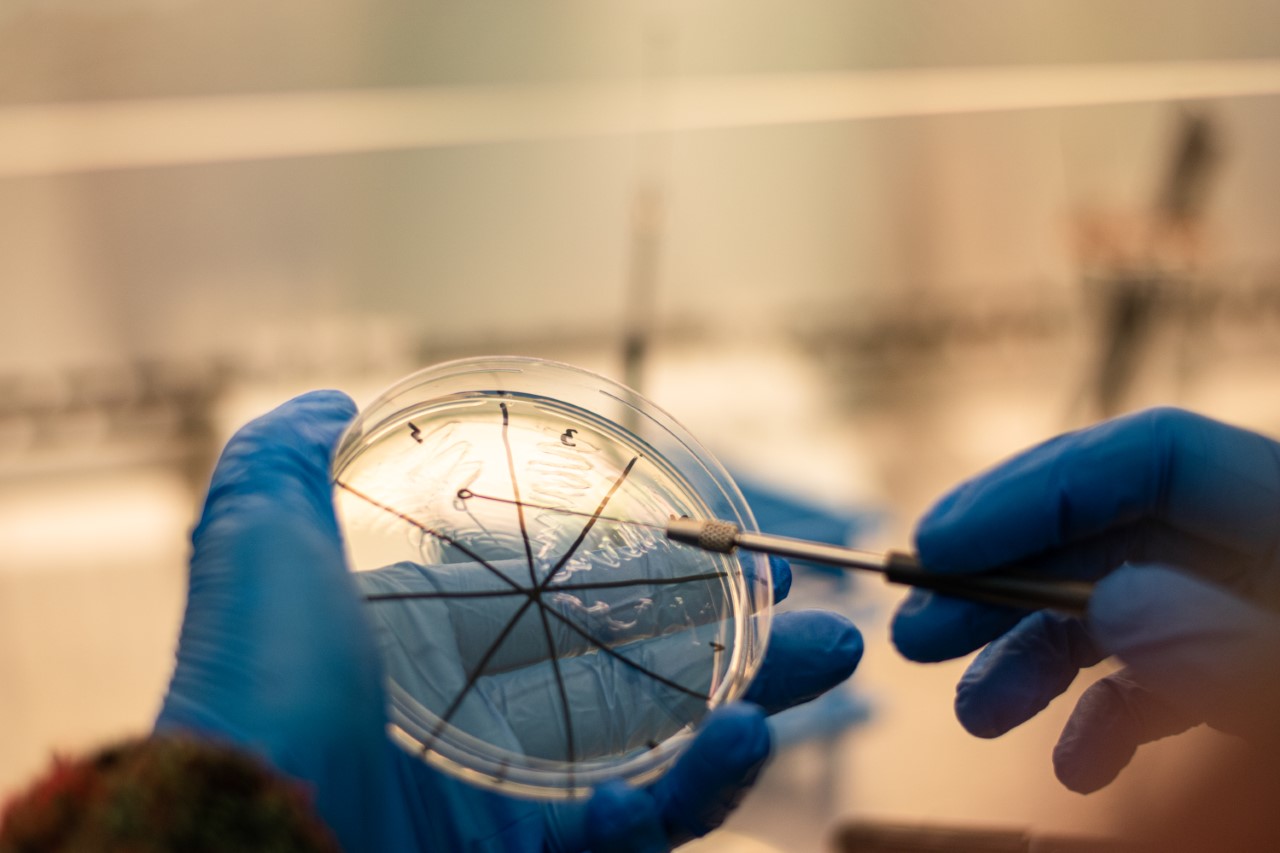
thumbnail_Riasy-3.jpg

SUA researchers test algae. They can be suitable as a functional food, but also as a helper for fruit growers
02.03.2023
Algae, especially spirulina and chlorella, contain large amounts of various important macro and micro elements, thanks to which the possibilities of their use increase.
Algae, especially spirulina and chlorella, contain large amounts of various important macro and micro elements, thanks to which the possibilities of their use increase.
SUA researchers - doctoral student Ing. Natália Čmiková under the guidance of supervisor prof. Miroslava Kačániová from the Institute of Horticulture, Faculty of Horticulture and Landscape Engineering are testing the antimicrobial activity of algae. The team of the AgroBioTech Research Centre in cooperation with Ing. Eva Ivanišová, PhD., from the Institute of Food Science, Faculty of Biotechnology and Food Sciences, focuses on the encapsulation of algae. Algae can be an excellent food supplement, but also a great helper for fruit growers.
It is known that bacteria become resistant to antibiotics, which is why our scientists are looking for new substitutes in the form of herbal extracts, essential oils and algae extracts.
The goal of Natália Čmiková's dissertation and research within the Horizon 2020 program under the auspices of the AgroBioTech RC is testing algae for antimicrobial properties, as well as searching for new natural ways of applying algae and extracts that could inhibit the growth of microorganisms, whether yeast, fungi or bacteria in people or plants. Currently, researchers are testing 30 extracts from ten types of algae - micro and macro algae and cyanobacteria - spirulina and chlorella.